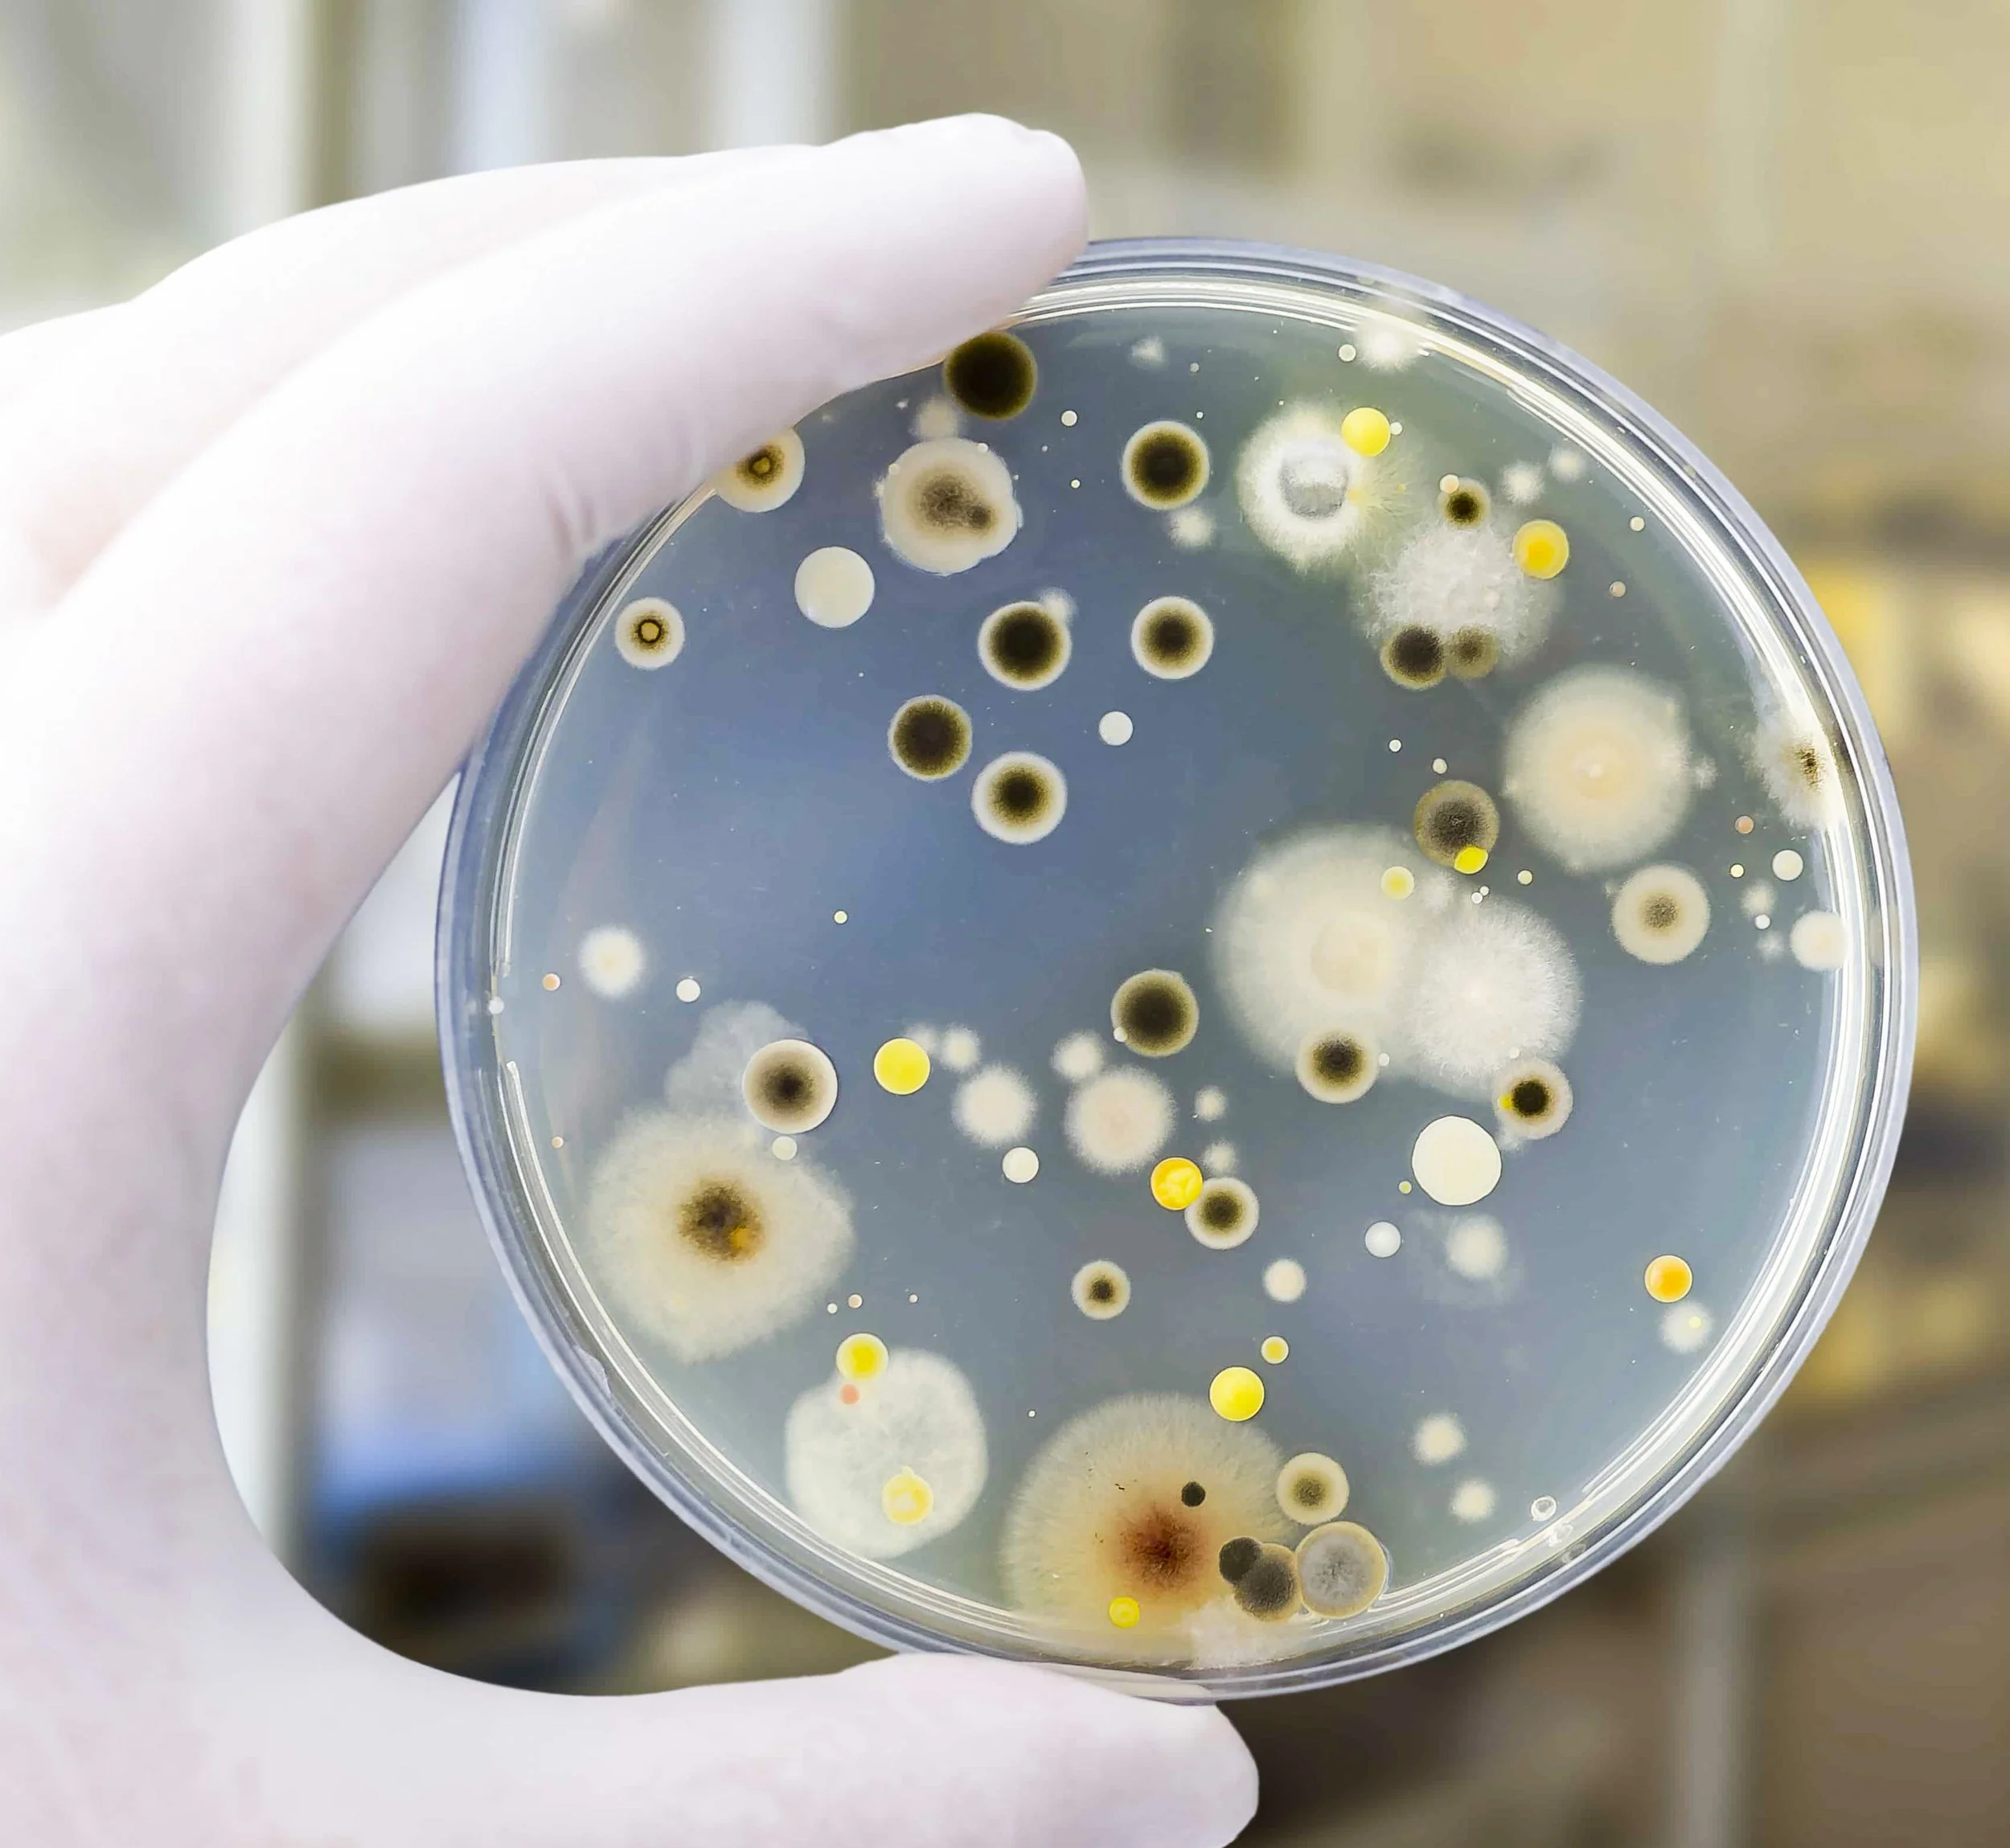

AIR QUALITY TEST


Indoor Air Quality (IAQ) Test
We offer Indoor Air Quality (IAQ) tests and mold inspections in Charlotte, NC and surrounding areas. People spend 90% of their time indoors. Indoor Air Quality impacts everyone, especially those who may be more vulnerable, such as children, the elderly, and people with health conditions like asthma and heart disease.
The quality of indoor air can be negatively affected by a wide range of sources, but the focus of testing centers around mold. There are 1,000’s of types of mold, and many of them can cause chronic allergic reactions that are easily mistaken for seasonal illnesses. Symptoms such as a runny nose, skin rashes, watery eyes, asthma, and sinus congestion can be caused by non-toxic varieties of mold in the home. Toxic varieties of mold have been linked to fatal illnesses. Individuals with compromised immune systems can be more susceptible to these conditions when exposed to mold than the average person.
Schedule online or get an instant online quote.


Mold In Our Environment
Molds are organisms that are found indoors and outdoors. They are part of the natural environment and play an important role in our ecological system by breaking down and digesting organic material. Mold spores cannot be eliminated from indoor environments. They find their way inside a home via air currents (opening a window or a door), a pet coming in and out, people coming in and out, etc.
The following conditions are necessary for mold growth to thrive on surfaces:
A temperature range between 40° F and 100° F;
The presence of mold spores;
A nutrient base (most surfaces contain nutrients);
Moisture
Apart from general cleanliness, the key to controlling mold growth in a home is to control moisture.

How Testing Works
If there are visible signs of apparent mold in the home, then a physical sample can be obtained and tested in a laboratory. However, often times the only evidence available is is a musty / damp odor. Because mold has a tendency to spread via airborne spores, testing for mold involves sampling the air to capture these spores. This is a very reliable method for determining what kind of mold issue the home has.
Below is a breakdown of the entire process:
Multiple air samples are taken, including one outdoor control.
Samples are priority shipped to a laboratory for analysis.
Results are available within 24-48 hours. A report is given by the laboratory that details the type, concentration, and location of mold spores.
A summary email is drafted for the client that contains two documents: A) Laboratory results B) An interpretation of the results. The interpretation document explains the results in layman’s terms. It also provides a wealth of information on maintaining healthy indoor air.

Helpful Resources
See below links for more information on Indoor Air Quality & Testing


